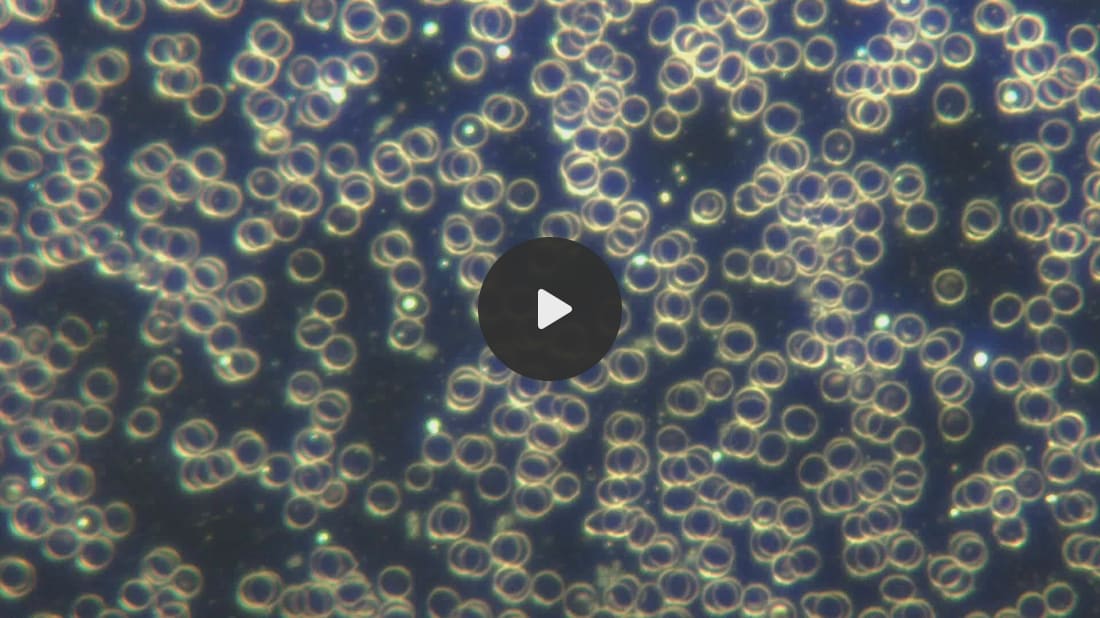
https%3A%2F%2Fsubstack-video.s3.amazonaws.com%2Fvideo_upload%2Fpost%2F146141247%2F8edc75be-ce9f-4732-9312-f116971d2fda%2Ftranscoded-00001.png

A Picture Can Speak a Thousand Words
You can check out Dr. Ana Maria’s and other Scientists’ Reports Summarized below the Image.
Dr. Ana Maria: “All aspects of this schematic have now been found in human blood –
Quantum Dots, hydrogel fibers, integrated circuits. I have shown this in multiple posts”
![]()
![]()
Dr. Pedro Chavez, who produced the brilliant documentary Bluetooth by Comusav, documented the MAC address phenomenon in the COVID 19 injected as well as the uninjected who received a PCR swab. He also showed that the graves of COVID 19 injected continue to emit MAC addresses. I am collaborating with Dr. Chavez and will have him on my Truth, Science and Spirit show soon for a not to be missed interview.
͏ ͏ ͏ ͏ ͏ ͏ ͏ ͏ ͏ ͏ ͏ ͏ ͏ ͏ ͏ ͏ ͏ ͏ ͏ ͏ ͏ ͏ ͏ ͏ ͏ ͏ ͏ ͏ ͏ ͏ ͏ ͏ ͏ ͏ ͏ ͏ ͏ ͏ ͏ ͏ ͏ ͏ ͏ ͏ ͏ ͏ ͏ ͏ ͏ ͏ ͏ ͏ ͏ ͏ ͏ ͏ ͏ ͏ ͏ ͏ ͏ ͏ ͏ ͏ ͏ ͏ ͏ ͏ ͏ ͏ ͏ ͏ ͏ ͏ ͏ ͏ ͏ ͏ ͏ ͏ ͏ ͏ ͏ ͏ ͏ ͏ ͏ ͏ ͏ ͏ ͏ ͏ ͏ ͏ ͏ ͏ ͏ ͏ ͏ ͏ ͏ ͏ ͏ ͏ ͏ ͏ ͏ ͏ ͏ ͏ ͏ ͏ ͏ ͏ ͏ ͏ ͏ ͏ ͏ ͏ ͏ ͏ ͏ ͏ ͏ ͏ ͏ ͏ ͏ ͏ ͏ ͏ ͏ ͏ ͏ ͏ ͏ ͏ ͏ ͏ ͏ ͏ ͏ ͏ ͏ ͏ ͏ ͏ ͏ ͏ ͏ ͏ ͏ ͏ ͏ ͏ ͏ ͏ ͏ ͏ ͏ ͏ ͏ ͏ ͏ ͏ ͏ ͏ ͏ ͏ ͏ ͏ ͏ ͏ ͏ ͏ ͏ ͏ ͏ ͏ ͏ ͏ ͏ ͏ ͏ ͏ ͏ ͏ ͏ ͏ ͏ ͏ ͏ ͏ ͏ ͏ ͏ ͏ ͏ ͏
Crimes Against Humanity In Progress: Correlation Of Historical Mik Anderson Presentation With The Self Assembly Nanotechnology Live Blood Findings Of The Past 3 years
Dr. Pedro Chavez, who produced the brilliant documentary Bluetooth by Comusav, documented the MAC address phenomenon in the COVID 19 injected as well as the uninjected who received a PCR swab. He also showed that the graves of COVID 19 injected continue to emit MAC addresses. I am collaborating with Dr. Chavez and will have him on my Truth, Science and Spirit show soon for a not to be missed interview. First, I have extensively documented Quantum Dot (QD) multi light frequency emitting microrobots in COVID 19 uninjected blood, and discussed the transmission via shedding of nanomaterials and filaments that are expelled through the skin and continue to self assemble in the body. The QD microcrobots also are part of self assembly mesogens and filaments and form electronic devices. These QD are known to pass the blood brain barrier.
Image: Quantum Dot Microrobots in COVID19 unvaccinated blood. AM Medical I have shown irrefutable video footage of it and correlated it with the technocratic globalist literature documentation of their plan of transforming humanity through graphene based nanorobots. The Argentinian Scientist group with Lorena Diblasi and Dr. Marcela Sangorrin have shown the fluorescent Graphene and presence of Lanthanide paramagnetic fluorescent metals used for semiconductor electronic in all COVID19 bioweapons used around the world. I have explained the significance of these findings in correlation to self assembly nanotechnology AI controlled biosensors and mesogen electronic devices. Of note, the combination of Graphene with Lanthanides metals has been explained to enhance fluorescence significantly. This is also correlated with the military literature.
I recently discussed the militarized cognitive warfare, the current medical literature showing that the COVID19 injected and those with Long COVID are verifiably cognitively impaired. I have also shown that the functional Brain EEG’s clearly show significant abnormalities. Prior history of COVID bioweapon infection symptoms, PCR testing, shedding and environmental contamination via geoengineering warfare all show the same symptomatology and are additive in their detrimental effects. As Mik Anderson described, the Quantum Dots, hydrogel polymers, nanonetwork routers ( mesogens and other self assembled devices) have all been found by me in COVID 19 unvaccinated blood as well.
I have also documented the nanoantennas found in injectable medications like Enbrel made by Pfizer:
I have shown electrical circuitry in this self assembled mesogen:
Image: COVID19 unvaccinated blood self assembled mesogen with interrated ciruits, polygon nanorouters. AM Medical
All aspects of this schematic have now been found in human blood – Quantum Dots, hydrogel fibers, integrated circuits. I have shown this in multiple posts:
Image: Filament coming out of a COVID19 unvaccinated individuals skin fluorescent under UV light shows integrated circuits. Magnification 4000x. AM Medical The mathematically fractal sheets were also seen in the Pfizer Enbrel injections used for autoimmune disease which has known microelectronics in the shots.
Image: Dried Pfizer Enbrel shows the crystalline microchip array of the self assembled nanoantennas – the crystals appear to have multicolored light emission (blue, violet, pink, gold). Magnification 2000x. AM Medical
In this interview with Maria Zeee from October 2022 I explain how the Carbon Nanotubes in the brain are the same size as microtubules in which consciousness is being processed. I explained then that a parallel processing platfrom is being built that is used for mind control and ultimately warfare on the soul. The Science of the C19 Nanotechnology and Quantum Physics – My Discussion with Maria Zeee Uncensored Dr Robert Duncan, from CIA and DARPA engineer confirmed these modalities as well as the ability to hack the human soul: This is the most important and concerning aspect of this technology, that it literally creates a new brain within the brain that then processes the mind control information coming from AI. Artificial neurons from Graphene are being produced.
Mik Anderson also confirmed that the nanosensors can embed themselves in the endothelial lining which would make sense since we see these Quantum Dot micorobots swim in the blood stream:
Video: Multiple Quantum Dot microrobots swimming in moving live blood in COVID19 unvaccinated individual. AM Medical. I also want to remind people that are still misunderstanding the spike protein as something having to do with a virus – it is not. The spike protein gene sequence has been shown to encode hydrogel polymer manufacturing at pH 7, hence it is a biosynthetic sequence programmed to manufacture technological components. Amyloid and Hydrogel Formation of a Peptide Sequence from a Coronavirus Spike Protein The Moderna patent as shown here by Karen Kingston also mentions hydrogel polymer presence as both encapsulation of the mmRNA ( genetically engineered synthetic biology) and the mmRNA itself.
Karen Kinstons also showed that the spike protein is a device that can be altered in electrical fields. This is not just a protein, it is an electronic nanotechnological DEVICE. We know that Graphene has been used for the synthesis of spike protein sequences.
Of course it is in the patents as well.
Summary: All aspects of the disclosure by Mik Anderson provided in 2021 have now been found and documented in COVID19 unjected blood from shedding and environmental sources. Wordwide scientists are showing the same findings. Experts like Karen Kingston also have provided supporting documentation to the reality of the full execution of this self assembly AI controlled technology in humanity. Humanity United Now – Ana Maria Mihalcea, MD, PhD is a reader-supported publication. To support my work, consider becoming a paid subscriber. You’re currently a free subscriber to Humanity United Now – Ana Maria Mihalcea, MD, PhD. For the full experience, upgrade your subscription.
© 2024 Ana Mihalcea, MD, PhD |
![]()
![]()
![]()
![]()